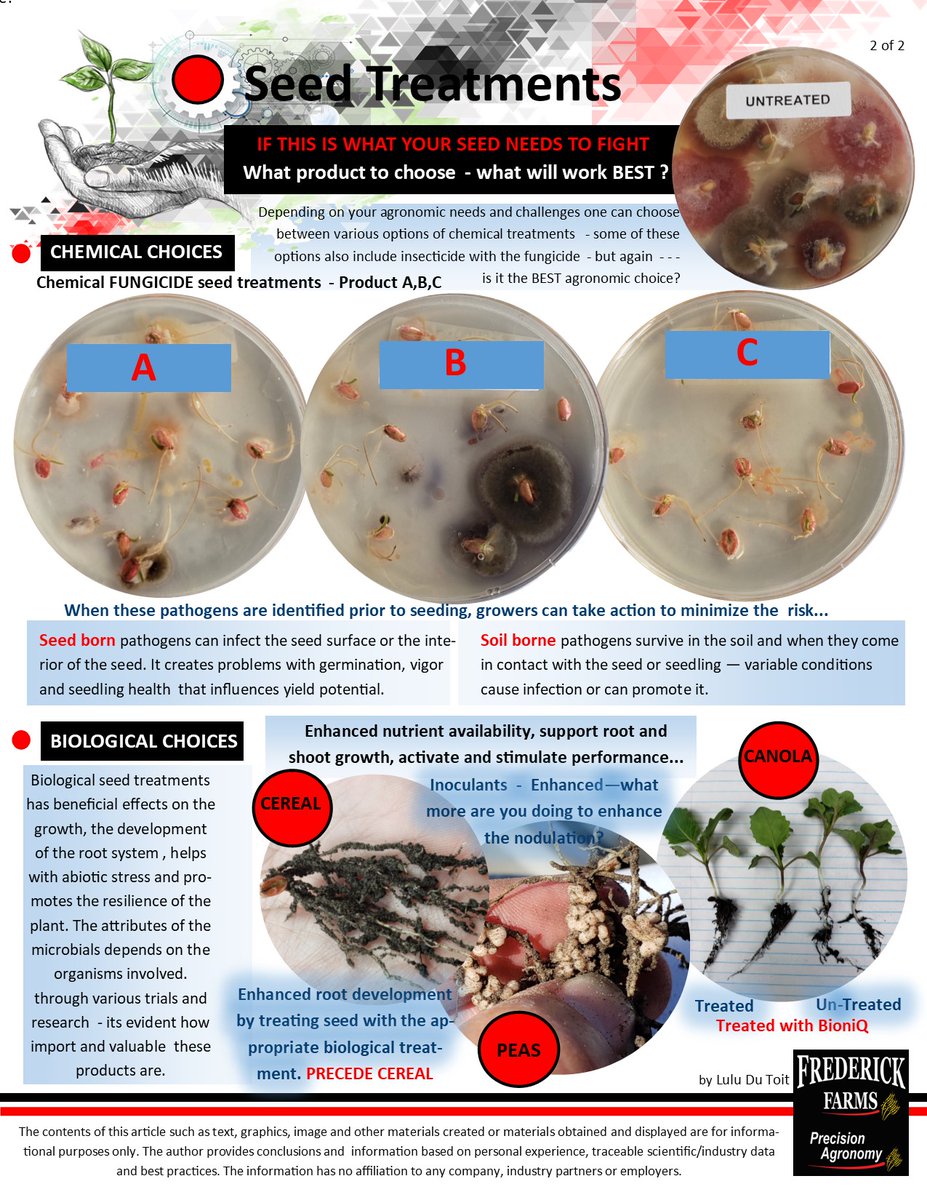
PrecisionAgFF's tweet image. The scoop on seed treatments ... Crop Production Chronicles #seedtreatment #farming #biological #fungicdes #agronomy

Some grain elevators use pneumatic truck probes to build composite samples that represent a truckload of grain. More information about pneumatic truck probe sampling: ow.ly/An5g50ImTqt #CdnAg
#DYK that we have a new Soil Fertility and Crop Rotation Planning publication? Specific rotations can impact diseases, insects, soil fertility and soil moisture. #SaskAg Check it out at: saskatchewan.ca/business/agric…

After a year of heat and drought, what might 2022 have in store? Join us for our February 15 Think Wheat webinar where agricultural meteorologist Drew Lerner of World Weather, Inc. will give an outlook on the 2022 weather trends. To register, go to us06web.zoom.us/webinar/regist…

There will be significant risks of herbicide carryover in 2022 due to the extreme heat and drought experienced in 2021. At our Feb 3 Think Wheat webinar, Clark Brenzil will discuss what producers need to be aware of prior to seeding. Register here: us06web.zoom.us/webinar/regist…

The Canola Research Hub is a knowledge transfer tool for growers, researchers & agronomists that defines scientific evidence-based best management practices for sustainable & profitable canola production. The latest post is now available at: canolacouncil.org/research-hub/

Year 3: fall rye has vigorous growth and allopathic effect. Year 4: flax or pea/mustard intercrop. #SaskAg saskatchewan.ca/business/agric…
NEWS RELEASE: SaskCanola has committed $1.14 million to 10 research projects funded under the Saskatchewan Agriculture Development Fund (ADF) in 2021 saskcanola.com/news/saskcanol… #canola #SaskAg #CdnAg

In 2020, Saskatchewan was Canada’s largest agri-food exporter to India, with exports of $498 million, and is India’s leading supplier of lentils and dry peas. #SaskAg saskatchewan.ca/business/agric…

The Grasshopper Forecast Map for 2022 is now available, #SaskAg. Note that localized hotspots may be under-represented due to their proximity to lower densities on the map. saskatchewan.ca/business/agric…

Happy International Split Pea week! In 2020, Saskatchewan farmers produced 2,477,600 metric tonnes of peas. Enjoy a bowl of pea soup today, #SaskAg. 🥣

In the first eight months of 2021, Saskatchewan’s agri-food exports have increased 10 per cent by value compared to the same period last year totaling $11.7 billion. #SaskAg #TradeStatTuesday

Dry field conditions may mean that soils have leftover nutrients. Make sure to soil test this fall #SaskAg to know what you’re starting with in 2022. saskatchewan.ca/business/agric…

#SaskAg, wondering about nutrients after this dry year? The only way to know for sure is to soil test after temperatures cool off. Learn more here: saskatchewan.ca/business/agric…

The targets outlined in the Saskatchewan Growth Plan map out our economic growth of the next 10 years. We’re on track to achieve them—and canola represents one of the key elements to their success. Read more about it in Agriview+ #SaskAg saskatchewan.ca/business/agric…

Time to hit the road! 🚛💨 This load of PhysioPro is on its way to a customer in Watson, Saskatchewan! It will help enhance plant development and trigger calcium absorption for their crop. ca.timacagro.com #ThinkDifferentFarmBetter #AgTwitter #CdnAg

If you do not have your midge tolerant wheat booked yet why not? Have you seen the 2021 forecast?

How does Midge Tolerant Wheat work? Find out:
The scoop on seed treatments ... Crop Production Chronicles #seedtreatment #farming #biological #fungicdes #agronomy

United States トレンド
- 1. FINALLY DID IT 148K posts
- 2. #NightOfTheSamurai 12.7K posts
- 3. Inoue 13.9K posts
- 4. Hernandez 17.3K posts
- 5. Good Saturday 25.9K posts
- 6. #天音かなた卒業ライブ 219K posts
- 7. Cherki 11.4K posts
- 8. President Holland N/A
- 9. Minnesota 635K posts
- 10. Elder Holland N/A
- 11. #MeAndTheeSeriesEP7 799K posts
- 12. Kanata 39.6K posts
- 13. #saturdaymorning N/A
- 14. Scissors 7,844 posts
- 15. Forest 82.9K posts
- 16. #RINGV 2,492 posts
- 17. Wordle 1,652 X N/A
- 18. Chiesa 6,478 posts
- 19. Somali 483K posts
- 20. FDNY 18.6K posts
Something went wrong.
Something went wrong.


















































